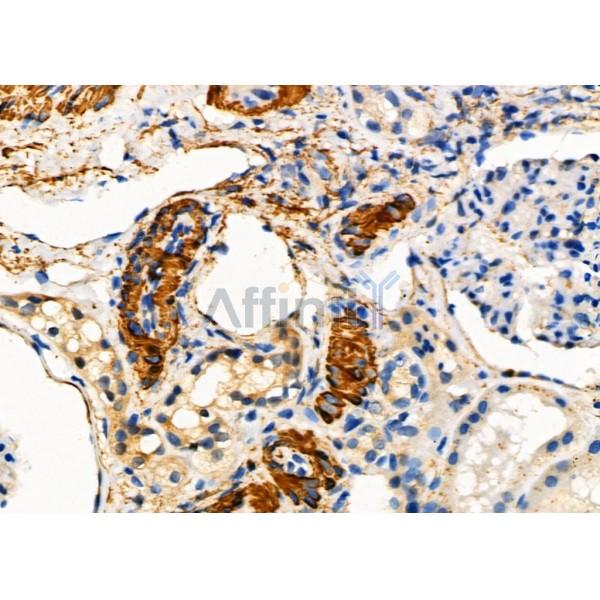
PAEP Antibody - DF2701 at 1/100 staining Human kidney cancer and adjacent normal tissues by IHC-P.

PAEP Antibody - #DF2701
| Product: | PAEP Antibody |
| Catalog: | DF2701 |
| Description: | Rabbit polyclonal antibody to PAEP |
| Application: | WB IHC |
| Reactivity: | Human, Rat |
| Mol.Wt.: | 21 kDa; 21kD(Calculated). |
| Uniprot: | P09466 |
| RRID: | AB_2839907 |
Related Downloads
Protocols
Product Info
*The optimal dilutions should be determined by the end user. For optimal experimental results, antibody reuse is not recommended.
*Tips:
WB: For western blot detection of denatured protein samples. IHC: For immunohistochemical detection of paraffin sections (IHC-p) or frozen sections (IHC-f) of tissue samples. IF/ICC: For immunofluorescence detection of cell samples. ELISA(peptide): For ELISA detection of antigenic peptide.
Cite Format: Affinity Biosciences Cat# DF2701, RRID:AB_2839907.
Fold/Unfold
Alpha uterine protein; gD; GdA; GdF; GdS; Glycodelin A; Glycodelin; Glycodelin F; Glycodelin S; MGC138509; MGC142288; PAEG; PAEP; PAEP_HUMAN; PEG; PEP; Placental protein 14; PP14; Pregnancy-associated endometrial alpha-2 globulin; Progestagen-associated endometrial protein; Progesterone-associated endometrial protein;
Immunogens
A synthesized peptide derived from human PAEP, corresponding to a region within N-terminal amino acids.
This protein is, the main protein synthesized and secreted in the endometrium from mid-luteal phase of the menstrual cycle and during the first semester of pregnancy (PubMed:3667877). Glycodelin-A is expressed in amniotic fluid, endometrium/decidua and maternal serum (at protein level) (PubMed:3194393). Glycodelin-F is expressed in follicular fluid, luteinized granulosa cells and the oviduct (at protein level) (PubMed:12672671). Glycodelin-S is expressed in seminal plasma and seminal vesicles (at protein level) (PubMed:9239694). Glycodelin-C is detected in cumulus cells (at protein level), but cumulus cells do not synthesize Glycodelin-C but take up and convert glycodelin-A and -F vis glycan remodeling (PubMed:17192260).
- P09466 PAEP_HUMAN:
- Protein BLAST With
- NCBI/
- ExPASy/
- Uniprot
MLCLLLTLGVALVCGVPAMDIPQTKQDLELPKLAGTWHSMAMATNNISLMATLKAPLRVHITSLLPTPEDNLEIVLHRWENNSCVEKKVLGEKTENPKKFKINYTVANEATLLDTDYDNFLFLCLQDTTTPIQSMMCQYLARVLVEDDEIMQGFIRAFRPLPRHLWYLLDLKQMEEPCRF
Research Backgrounds
Glycoprotein that regulates critical steps during fertilization and also has immunomonomodulatory effects. Four glycoforms, namely glycodelin-S, -A, -F and -C have been identified in reproductive tissues that differ in glycosylation and biological activity. Glycodelin-A has contraceptive and immunosuppressive activities. Glycodelin-C stimulates binding of spermatozoa to the zona pellucida. Glycodelin-F inhibits spermatozoa-zona pellucida binding and significantly suppresses progesterone-induced acrosome reaction of spermatozoa. Glycodelin-S in seminal plasma maintains the uncapacitated state of human spermatozoa.
Four distinct glycoforms A, C, F and S arise from different N-linked oligosaccharide chains at amino acid residues Asn-46 and Asn-81. Glycodelin-A and -F are taken up by the cumulus cells in which partial deglycosylation takes place to produce glycodelin-C.
Secreted.
This protein is, the main protein synthesized and secreted in the endometrium from mid-luteal phase of the menstrual cycle and during the first semester of pregnancy. Glycodelin-A is expressed in amniotic fluid, endometrium/decidua and maternal serum (at protein level). Glycodelin-F is expressed in follicular fluid, luteinized granulosa cells and the oviduct (at protein level). Glycodelin-S is expressed in seminal plasma and seminal vesicles (at protein level). Glycodelin-C is detected in cumulus cells (at protein level), but cumulus cells do not synthesize Glycodelin-C but take up and convert glycodelin-A and -F vis glycan remodeling.
Belongs to the calycin superfamily. Lipocalin family.
Restrictive clause
Affinity Biosciences tests all products strictly. Citations are provided as a resource for additional applications that have not been validated by Affinity Biosciences. Please choose the appropriate format for each application and consult Materials and Methods sections for additional details about the use of any product in these publications.
For Research Use Only.
Not for use in diagnostic or therapeutic procedures. Not for resale. Not for distribution without written consent. Affinity Biosciences will not be held responsible for patent infringement or other violations that may occur with the use of our products. Affinity Biosciences, Affinity Biosciences Logo and all other trademarks are the property of Affinity Biosciences LTD.